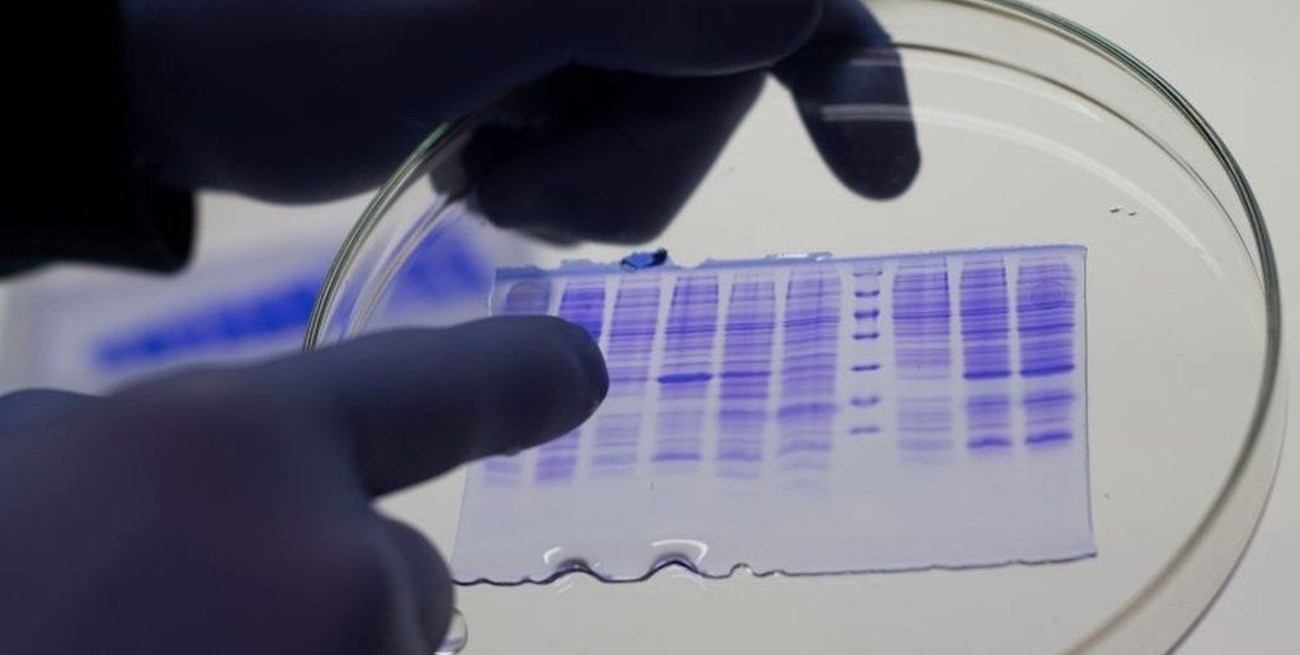

Por Juan Chiummiento
Coronavirus: el antiviral de un laboratorio santafesino obtuvo 97% de eficiencia en Fase 1
Una empresa ubicada en Cañada de Gómez avanzará ahora con la etapa de prueba en animales. Lo hará junto al instituto Malbrán.

Radicada en Cañada de Gómez desde 1985, la empresa Nova se abocó desde siempre al desarrollo de agroquímicos. Sin embargo, con el correr de los años fue ampliando su paleta de productos, al punto de abrir en 2013 una división vinculada a la producción de enzimas para el sector industrial.
El año pasado, durante las primeras semanas de la pandemia, anunció el inicio de una investigación destinada a desarrollar un antiviral contra el coronavirus. Tras una primera etapa exitosa, la firma acaba de sellar un convenio con el instituto Malbrán para avanzar en la segunda fase del proyecto, que se realiza sobre animales. En caso de tener éxito luego vendría una tercera, en donde participarían voluntarios humanos.
Amén del buen desempeño que viene teniendo la investigación, desde la empresa prefieren mostrar, antes que nada, cautela: “La eficiencia alta que obtuvimos en la primera etapa no nos asegura nada respecto a que en la segunda tengamos éxito”, dice su CEO, Mauro Piva, en diálogo con Mirador Provincial. En el proyecto trabaja un equipo de biotecnológicos e ingenieros químicos, quienes desarrollan proteínas con potencial efecto viral contra el Covid-19.

“Se trata de proteínas que actúan interfiriendo la conexión del virus con las células. Lo que hace esta proteína es evitar esa conexión entre el virus y las células madre”, explica Piva. De confirmarse que sean efectivas, las proteínas podrían constituir la base para el desarrollo de un fármaco similar al que por estas semanas se conoció por parte de la estadounidense Pfizer (trascendió que ya lo está probando en personas adultas y que podría estar disponible para finales de año).
Durante la primera etapa -denominada “in vitro”, puertas adentro del laboratorio-, la investigación de la firma cañadense se realizó junto con el Instituto de Virología y Retrovirus. Las pruebas resultaron exitosas, con un 97% de eficiencia. El próximo paso es la realización de ensayos en animales, fase que Nova realizará junto a la Administración Nacional de Laboratorios e Institutos de Salud “Dr. Carlos Malbrán”, un organismo público dependiente del Ministerio de Salud nacional, que ganó fuerte repercusión el último año de pandemia.
“Hay varias empresas en el mundo desarrollando antivirales. Hay que recordar que mientras que las vacunas tienen efecto preventivo, los antivirales tienen uno ya creativo”, detalla el CEO de Nova, que el año pasado recibió la visita del gobernador Omar Perotti cuando se inauguró una planta piloto destinada a la producción de proteínas y otras moléculas, que se llevó a cabo tras una inversión de 12 millones de dólares.
Según comunicó la empresa el año pasado, las estadísticas globales hablan que los desarrollos de biotecnología tienen un pequeño margen de éxito. Tan solo el 3% de los proyectos llega al proceso final, por lo que la carrera entre esta etapa y la posible producción en serie puede ser muy extensa.

Amplio portfolio
El laboratorio Nova es una empresa con más de 35 años en el mercado, que produce más de 100 productos sumando a las diferentes familias de fitosanitarios (coadyuvantes, inoculantes, terápicos de semillas, funguicidas, fertilizantes, insecticidas y herbicidas). Desde 2013 han diversificado la firma, apostando a nuevas tecnologías y mercados.
La empresa invirtió en biotecnología aplicada a la producción de proteínas (enzimas) para diferentes usos y rubros. Han desarrollado enzimas relacionadas al rubro alimenticio (quimosina para producción de quesos y lactasa para producción de dulce de leche); otras que se aplican a la producción de bioetanol (amilasa y glucoamilasa); y otras destinadas a la alimentación animal (cerdos y aves).
Según comunicó oficialmente a finales del año pasado, cuenta con 180 personas en las diferentes áreas de trabajo. Opera con más de 700 distribuidores en toda la Argentina y hace siete años desarrollaron un equipo de comercio exterior que opera en más de 12 países.